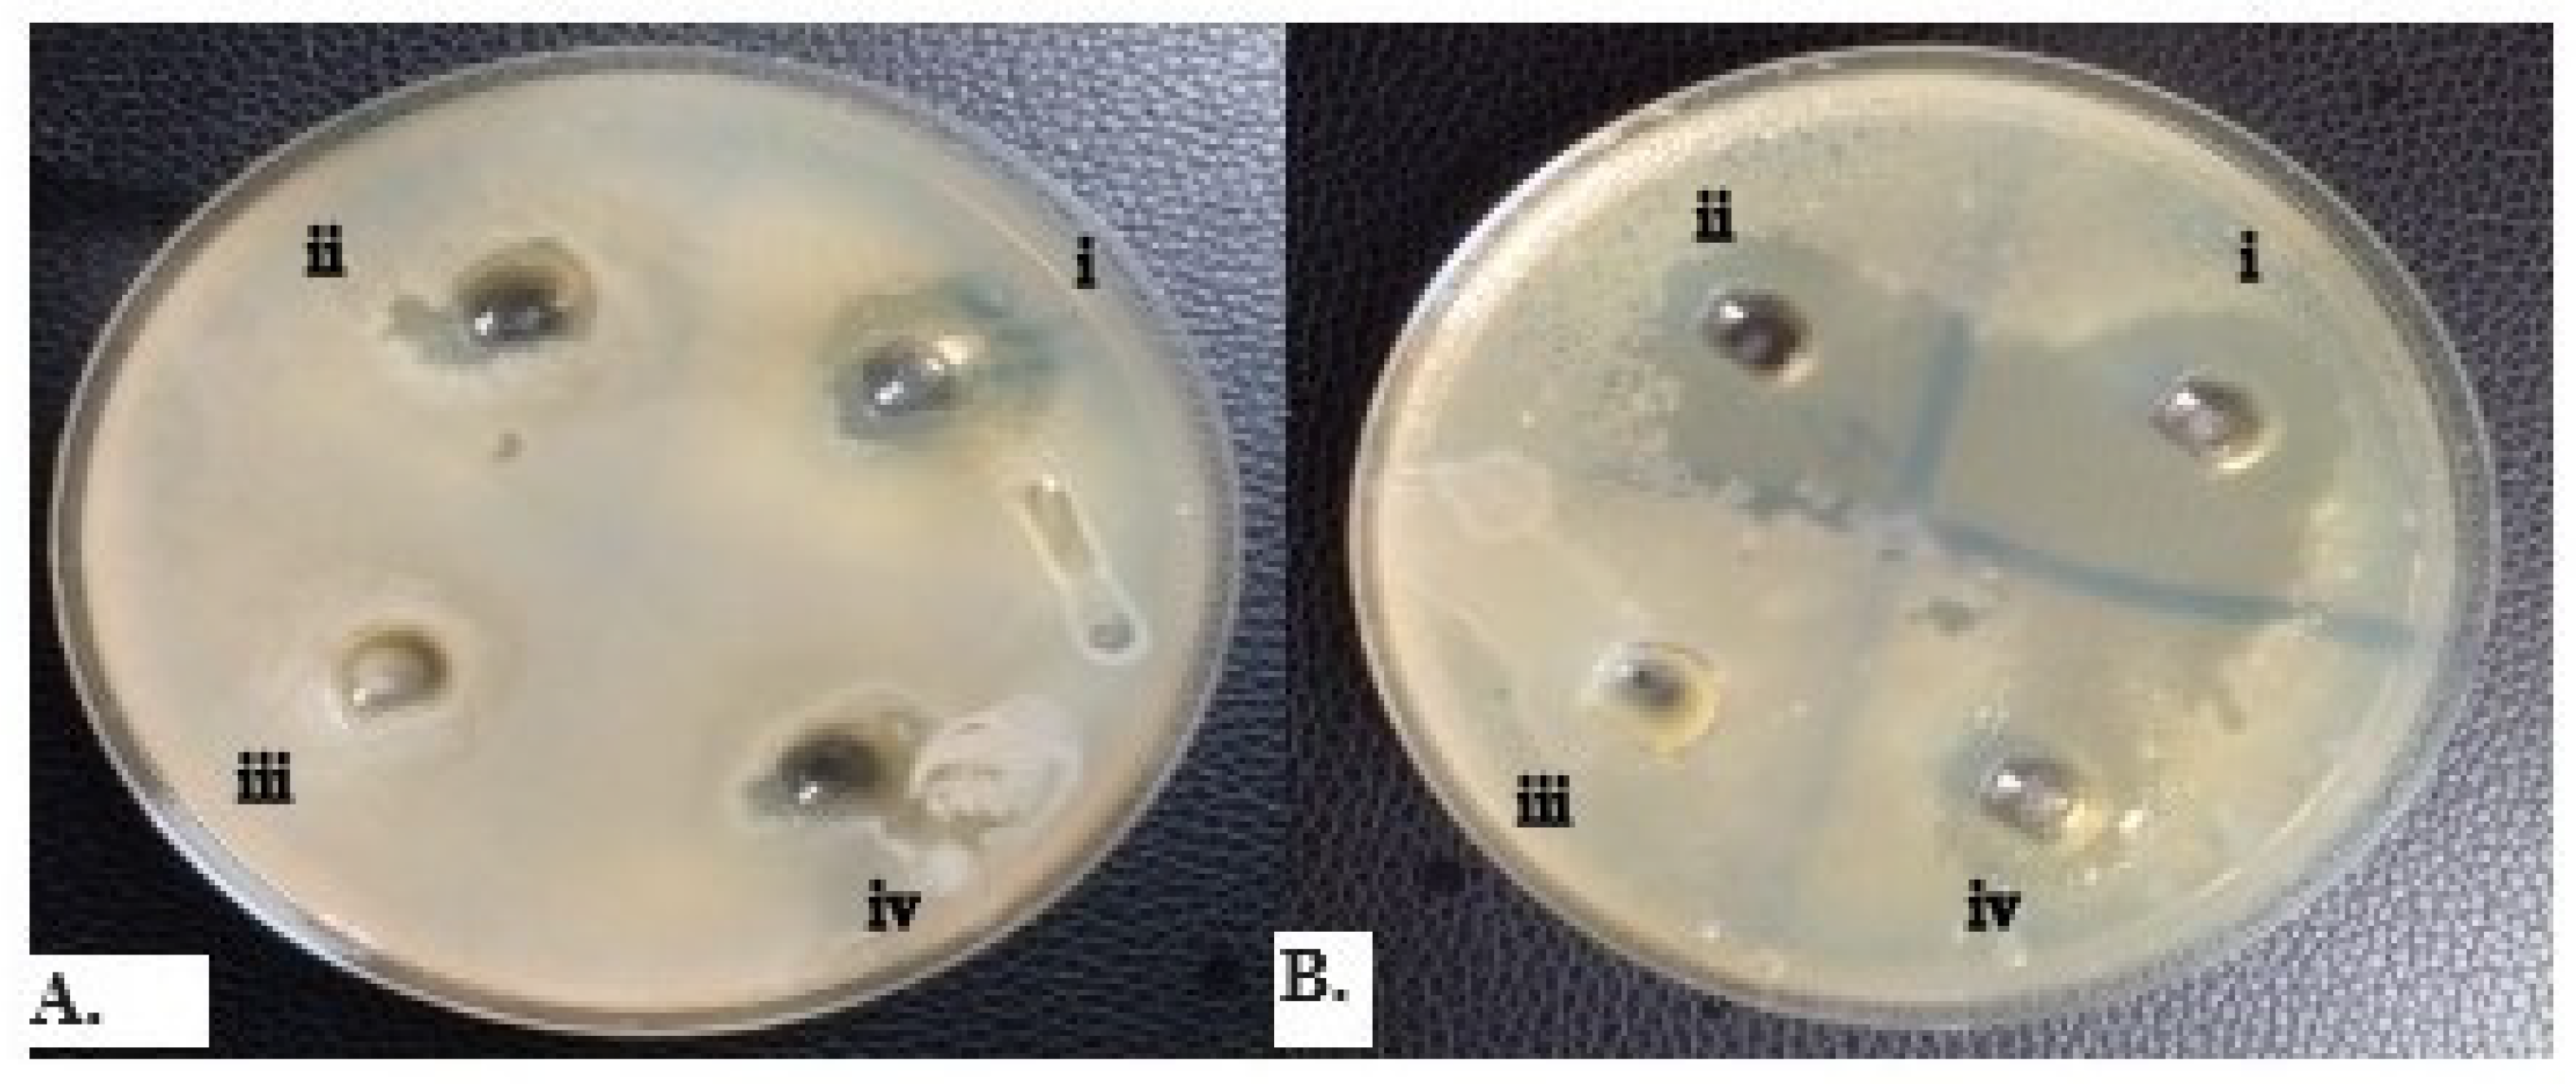
Gels 09 00949 g002
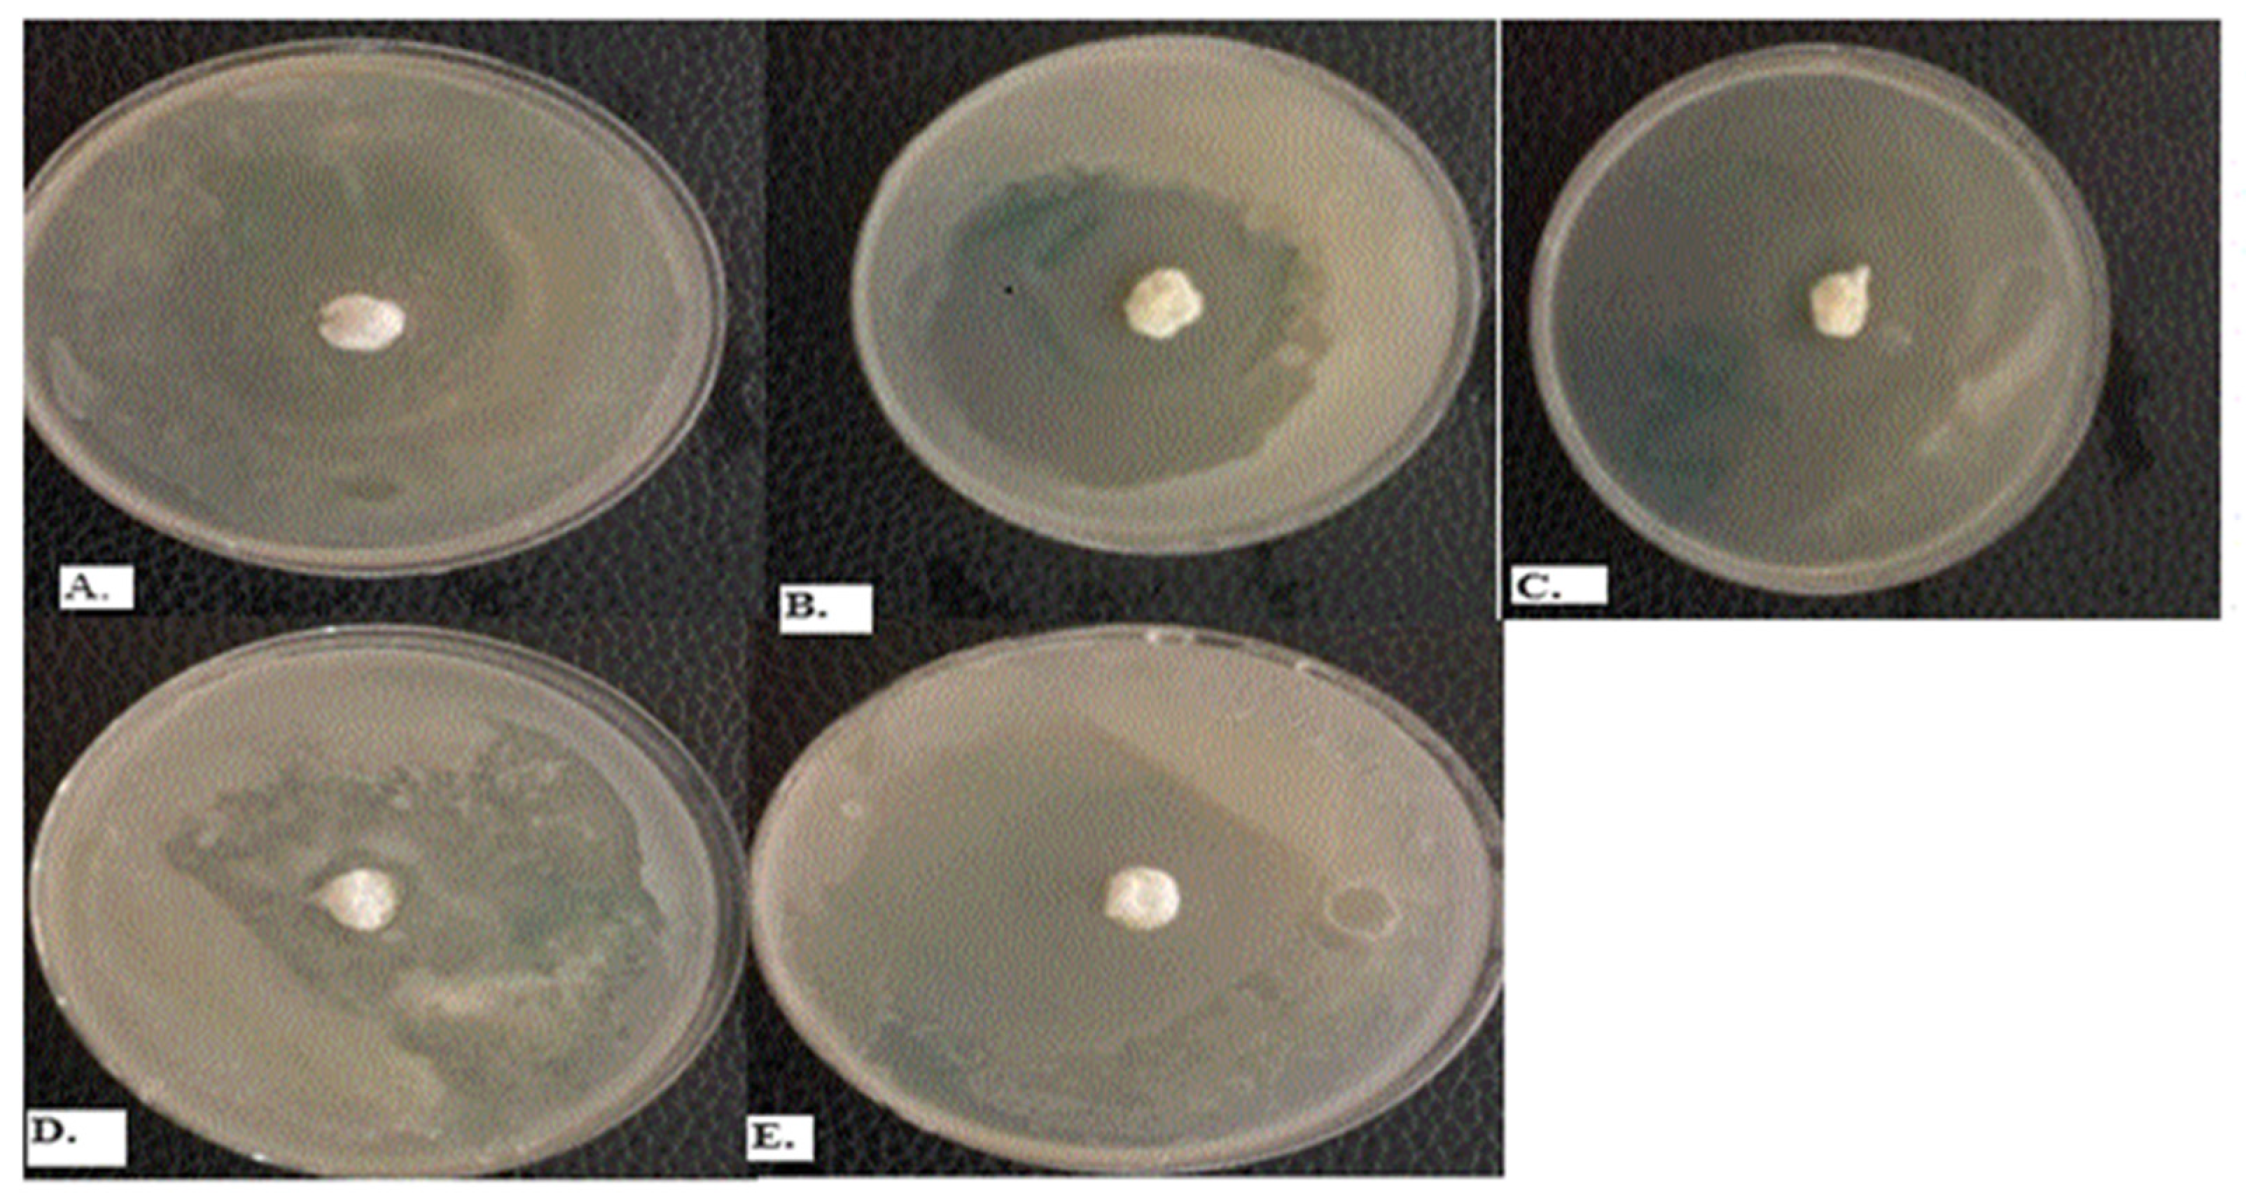
Gels 09 00949 g003

The Formulation and Evaluation of Melaleuca alternifolia Cheel and Cymbopogon flexuosus Linn Essential Oils Emulgel for the Treatment of Vulvovaginal Candidiasis
Abstract
:1. Introduction
2. Results and Discussion
2.1. Physicochemical Analysis of the Essential Oils of Melaleuca alternifolia and Cymbopogon flexuosus
2.2. Distribution of Vagina Candidiasis among Collected Samples
2.3. Antifungal Susceptibility Testing of Yeast Isolates
2.4. Minimum Inhibitory Concentration (MIC) of Essential Oils
2.5. Synergistic Action of Melaleuca Alternifolia and Cymbopogon flexuosus Essential Oils in Combination
2.6. Post-Formulation Antifungal Activity
2.7. Pseudo-Ternary Phase Diagram
2.8. Physicochemical Properties of Emulgel Preparation
2.9. Stability Testing of the Formulations
2.10. Viscosity Evaluation of the Formulations
3. Conclusions
4. Materials and Methods
4.1. Materials, Equipment, and Isolates
4.2. Ethical Considerations
4.3. Study Criteria (for Vaginal Swab Collection)
4.4. Physicochemical Analysis of Essential Oil
4.5. Determination of Organoleptic Properties of the Essential Oils
4.6. Microbiological Analysis
4.6.1. Collection of Vaginal Swabs
4.6.2. Isolation and Identification of Candida albicans
4.6.3. Determination of Inoculum Size
4.7. Antifungal Assay
4.7.1. Screening for Antifungal Activity of Essential Oils
4.7.2. Determination of Minimum Inhibitory Concentrations (MIC) of the Essential Oils
4.7.3. Determination of Synergism of the Combination of the Essential Oils
4.8. Pharmaceutical Analysis for Formulation of Emulgel
4.8.1. Drug–Excipient Compatibility Study
4.8.2. Pseudo-Ternary Phase Diagrams for Emulsion
4.8.3. Determination of the Amount of Surfactant and co Surfactant for the Preparation of Emulsion Using the HLB System
4.9. Formulation of the Essential Oil Emulgel
4.10. Characterization of the Emulgel
4.10.1. Physical Appearance
4.10.2. pH Measurement
4.10.3. Viscosity
4.10.4. Stability Test
4.10.5. Determination of Homogeneity
4.11. Post-Formulation Antifungal Analysis of Emulgels
Author Contributions
Funding
Institutional Review Board Statement
Informed Consent Statement
Data Availability Statement
Acknowledgments
Conflicts of Interest
References
- Mahato, R.I.; Narang, A.S. Pharmaceutical Dosage Forms and Drug Delivery: Revised and Expanded, 3rd ed.; CRC Press: Boca Raton, FL, USA, 2017. [Google Scholar] [CrossRef]
- Yadav, S.K.; Mishra, M.K.; Tiwari, A.; Shukla, A. Emulgel: A new approach for enhanced topical drug delivery. Int. J. Curr. Pharm. Res. 2016, 9, 15–19. [Google Scholar] [CrossRef]
- Talat, M.; Zaman, M.; Khan, R.; Jamshaid, M.; Akhtar, M.; Mirza, A.Z. Emulgel: An effective drug delivery system. Drug Dev. Ind. Pharm. 2021, 47, 1193–1199. [Google Scholar] [CrossRef]
- Begum, S.G.; Chetty, C.M.; Pavithra, B.; Akhila, B.; Gayathri, C.; Ruksar, S.; Sravani, T.; Voleti, V.K. A Review On Emulgels-A Novel Approach for Topical Drug Delivery. Asian J. Pharm. Res. Dev. 2019, 7, 70–77. [Google Scholar] [CrossRef]
- Osmałek, T.; Froelich, A.; Jadach, B.; Tatarek, A.; Gadziński, P.; Falana, A.; Gralińska, K.; Ekert, M.; Puri, V.; Wrotyńska-Barczyńska, J.; et al. Recent Advances in Polymer-Based Vaginal Drug Delivery Systems. Pharmaceutics 2021, 13, 884. [Google Scholar] [CrossRef]
- Johal, H.S.; Garg, T.; Rath, G.; Goyal, A.K. Advanced Topical Drug Delivery System for the Management of Vaginal Candidiasis. Drug Deliv. 2016, 23, 550–563. [Google Scholar] [CrossRef]
- Moyes, D.L.; Wilson, D.; Richardson, J.P.; Mogavero, S.; Tang, S.X.; Wernecke, J.; Höfs, S.; Gratacap, R.L.; Robbins, J.; Runglall, M.; et al. Candidalysin is a fungal peptide toxin critical for mucosal infection. Nature 2016, 532, 64–68. [Google Scholar] [CrossRef] [PubMed]
- Odds, F.C. Candida and Candidiasis, 2nd ed.; CRC Press: Boca Raton, FL, USA, 2019. [Google Scholar]
- Sobel, J.D. Candida vulvovaginitis. Lancet 2016, 387, 1999–2007. [Google Scholar] [CrossRef] [PubMed]
- Pappas, P.G.; Kauffman, C.A.; Andes, D.R.; Clancy, C.J.; Marr, K.A.; Ostrosky-Zeichner, L.; Reboli, A.C.; Schuster, M.G.; Vazquez, J.A.; Walsh, T.J.; et al. Clinical Practice Guideline for the Management of Candidiasis: 2016 Update by the Infectious Diseases Society of America. Clin. Infect. Dis. 2016, 62, e1–e50. [Google Scholar] [CrossRef] [PubMed]
- Kridin, K.; Bergman, R. Candida nail infection: A review of current concepts. Mycoses 2019, 62, 664–672. [Google Scholar] [CrossRef]
- Kollef, M.H.; Micek, S.T.; Hampton, N.; Doherty, J.A. Septic shock attributed to Candida infection: Importance of empiric therapy and source control. Clin. Infect. Dis. 2019, 68, 1985–1990. [Google Scholar] [CrossRef]
- Martin Lopez, J.E. Candidiasis (vulvovaginal). BMJ Clin. Evid. 2015, 2015, 0815. [Google Scholar] [PubMed]
- Yano, J.; Sobel, J.D.; Nyirjesy, P.; Sobel, R.; Williams, V.L.; Yu, Q.; Noverr, M.C.; Fidel, P.L. Current patient perspectives of vulvovaginal candidiasis: Incidence, symptoms, management, and post-treatment outcomes. BMC Women’s Health 2019, 19, 48. [Google Scholar] [CrossRef] [PubMed]
- Nyirjesy, P.; Brookhart, C.; Lazenby, G.; Schwebke, J.; Sobel, J.D. Vulvovaginal Candidiasis: A Review of the Evidence for the 2021 Centers for Disease Control and Prevention of Sexually Transmitted Infections Treatment Guidelines. Clin. Infect. Dis. 2022, 74 (Suppl. 2), S162–S168. [Google Scholar] [CrossRef] [PubMed]
- Nasrollahi, Z.; Yadegari, M.H.; Roudbar Mohammadi, S.; Roudbary, M.; Hosseini Poor, M.; Nikoomanesh, F.; Rajabi Bazl, M. Fluconazole Resistance Candida albicans in Females with Recurrent Vaginitis and Pir1 Overexpression. Jundishapur J. Microbiol. 2015, 8, e21468. [Google Scholar] [CrossRef] [PubMed]
- Yang, M.; Cao, Y.; Zhang, Z.; Guo, J.; Hu, C.; Wang, Z.; Du, Y. Low intensity ultrasound-mediated drug-loaded nanoparticles intravaginal drug delivery: An effective synergistic therapy scheme for treatment of vulvovaginal candidiasis. J. Nanobiotechnol. 2023, 21, 53. [Google Scholar] [CrossRef]
- Rusda, M.; Ganis Siregar, M.F.; Lelo, A.; Ilyas, S.; Akbari Ganie, R.; Effendi, Y.; Zaitun Hasibuan, P.A.; Lia Iswara, R.R. A therapeutic effect of Nigella sativa extract on female Wistar rats’ vulvovaginal candidiasis model. Med. Glas. 2020, 17, 472–476. [Google Scholar] [CrossRef]
- Córdoba, S.; Vivot, W.; Szusz, W.; Albo, G. Antifungal Activity of Essential Oils Against Candida Species Isolated from Clinical Samples. Mycopathologia 2019, 184, 615–623. [Google Scholar] [CrossRef]
- Macwan, S.; Dabhi, B.; Aparnathi, K.; Prajapati, J. Essential Oils of Herbs and Spices: Their Antimicrobial Activity and Application in Preservation of Food. Int. J. Curr. Microbiol. Appl. Sci. 2016, 5, 885–901. [Google Scholar] [CrossRef]
- Hanif, M.; Nawaz, H.; Khan, M.M.; Byrne, H.J. Medicinal Plants of South Asia; Elsevier: Amsterdam, The Netherlands, 2019. [Google Scholar]
- Borotova, P.; Galovicova, L.; Vukovic, N.L.; Vukic, M.; Tvrda, E.; Kacaniova, M. Chemical and biological characterization of Melaleuca alternifolia essential oil. Plants 2022, 11, 558. [Google Scholar] [CrossRef]
- de Melo, A.M.; Barbi, R.C.T.; Chaves Almeida, F.L.; de Souza, W.F.C.; de Melo Cavalcante, A.M.; de Souza, H.J.B.; Botrel, D.A.; Borges, S.V.; Costa, R.G.; Quirino, M.R.; et al. Effect of Microencapsulation on Chemical Composition and Antimicrobial, Antioxidant and Cytotoxic Properties of Lemongrass (Cymbopogon flexuosus) Essential Oil. Food Technol. Biotechnol. 2022, 60, 386–395. [Google Scholar] [CrossRef]
- Venugopal, D.; Husain, K.; Mustafa, S.A.; Sabeen, S. Epidemiology, risk factors and antimicrobial profile of Vulvovaginal Candidiasis (VVC): A study among women in the central region of Saudi Arabia. J. Med. Mycol. 2020, 31, 101049. [Google Scholar] [CrossRef] [PubMed]
- Disha, T.; Haque, F. Prevalence and Risk Factors of Vulvovaginal Candidosis during Pregnancy: A Review. Infect. Dis. Obstet. Gynecol. 2022, 2022, e6195712. [Google Scholar] [CrossRef] [PubMed]
- Shazadi, K.; Liaqat, I.; Mehreen, A.; Arshad, N. Comparison and Association between Different Types of Vaginitis and Risk Factors among Reproductive Aged Women in Lahore, Pakistan: A Cross-Sectional Study. Braz. Arch. Biol. Technol. 2022, 65, 1–11. [Google Scholar] [CrossRef]
- Chuku, A.; Yami, L.; Bukola, A. Prevalence of Candida Species from Cases of Vulvovaginitis in Women using Contraceptives in Four Selected States of North Central Nigeria. J. Adv. Microbiol. 2019, 18, 1–10. [Google Scholar] [CrossRef]
- Soliman, S.; Alnajdy, D.; El-Keblawy, A.; Mosa, K.; Khoder, G.; Noreddin, A. Plants’ natural products as alternative promising anti-Candida drugs. Pharmacogn. Rev. 2017, 11, 104. [Google Scholar] [CrossRef] [PubMed]
- Talapko, J.; Juzbašić, M.; Matijević, T.; Pustijanac, E.; Bekić, S.; Kotris, I.; Škrlec, I. Candida albicans-the virulence factors and clinical manifestations of infection. J. Fungi 2021, 7, 79. [Google Scholar] [CrossRef] [PubMed]
- Jahdi, F.; Hamzehgardeshi, Z.; Kuolaei, M.D.; Vahedi, M.; Goodarzi, S. Vulvovaginal Candidiasis Symptom Reduction—Honey, Yogurt-and-Honey and Clotrimazole Vaginal Cream—A Triple Blind Randomized Control Trial. J. Evol. Med. Dent. Sci. 2021, 10, 515–521. [Google Scholar] [CrossRef]
- Biernasiuk, A.; Malm, A. Synergistic Interactions between Linalool and Some Antimycotic Agents against Candida spp. as a Basis for Developing New Antifungal Preparations. Appl. Sci. 2023, 13, 5686. [Google Scholar] [CrossRef]
- Ahmed, S.; Verma, S.; Khan, S.A.; Sharma, A. Emulgel: A revolution in topical drug delivery system. Int. J. Health Sci. (IJHS) 2022, 6, 10834–10856. [Google Scholar] [CrossRef]
- Dahham, M.T.; Omar, F.A.; Dheeb, B.I. Synergistic effect of tea tree oil on fungi causing vaginal thrush in pregnant women. J. Biotechnol. Res. Cent. 2019, 13, 35–44. [Google Scholar] [CrossRef]
- Shah, G.; Shri, R.; Panchal, V.; Sharma, N.; Singh, B.; Mann, A. Scientific basis for the therapeutic use of Cymbopogon citratus, stapf (Lemon grass). J. Adv. Pharm. Technol. Res. 2011, 2, 3. [Google Scholar] [CrossRef]
- Toungos, M.D. Lemongrass (Cymbopogon, L. Spreng) valuable grass but underutilized in Northern Nigeria. Int. J. Innov. Food Nutr. Sustain. Agric. 2019, 7, 6–14. [Google Scholar]
- de Bona da Silva, C.; Guterres, S.S.; Weisheimer, V.; Schapoval, E.E.S. Antifungal activity of the lemongrass oil and citral against Candida spp. Braz. J. Infect. Dis. 2008, 12, 63–66. [Google Scholar] [CrossRef]
- Li, Y.; Shao, X.; Xu, J.; Wei, Y.; Xu, F.; Wang, H. Tea tree oil exhibits antifungal activity against Botrytis cinerea by affecting mitochondria. Food Chem. 2017, 234, 62–67. [Google Scholar] [CrossRef]
- O’Hanlon, D.E.; Come, R.A.; Moench, T.R. Vaginal pH measured in vivo: Lactobacilli determine pH and lactic acid concentration. BMC Microbiol. 2019, 19, 13. [Google Scholar] [CrossRef] [PubMed]
- Maesaroh, I.; Pratiwi, D.; Agustin, L. Ointment Formulation and Test Preparation from Manilkara zapota L. Leaf Extract Using Variation of Ointment Base as Boils. Indones. J. Pharm. 2020, 2, 14–19. [Google Scholar]
- Denamur, E.; Bonacorsi, S.; Giraud, A.; Duriez, P.; Hilali, F.; Amorin, C.; Bingen, E.; Andremont, A.; Picard, B.; Taddei, F.; et al. High frequency of mutator strains among human uropathogenic Escherichia coli isolates. J. Bacteriol. 2002, 184, 605–609. [Google Scholar] [CrossRef]
- Zhang, Z.; Mo, Z.; Zhang, X.; Wang, J.; Li, J.; Shi, H.; Wang, P.; Lin, Z. The antifungal activity and action mechanism of lemongrass (Cymbopogon flexuosus) essential oil against Fusarium avenaceum. J. Essent. Oil-Bear. Plants 2022, 25, 536–547. [Google Scholar] [CrossRef]
- Yu, D.; Wang, J.; Shao, X.; Xu, F.; Wang, H. Antifungal modes of action of tea tree oil and its two characteristic components against Botrytis cinerea. J. Appl. Microbiol. 2015, 119, 1253–1262. [Google Scholar] [CrossRef]
- Endo, E.H.; Cortez, D.A.; Ueda-Nakamura, T.; Nakamura, C.V.; Dias Filho, B.P. Potent antifungal activity of extracts and pure compound isolated from pomegranate peels and synergism with fluconazole against Candida albicans. Res. Microbiol. 2010, 161, 534–540. [Google Scholar] [CrossRef]
- Zekri, N.; Elazzouzi, H.; Ailli, A.; Gouruch, A.A.; Radi, F.Z.; El Belghiti, M.A.; Zair, T.; Nieto, G.; Centeno, J.A.; Lorenzo, J.M. Physicochemical Characterization and Antioxidant Properties of Essential Oils of M. pulegium (L.), M. suaveolens (Ehrh.) and M. spicata (L.) from Moroccan Middle-Atlas. Foods 2023, 12, 760. [Google Scholar] [CrossRef] [PubMed]
- Waikhom, S.D.; Afeke, I.; Kwawu, G.S.; Mbroh, H.K.; Osei, G.Y.; Louis, B.; Deku, J.G.; Kasu, E.S.; Mensah, P.; Agede, C.Y.; et al. Prevalence of vulvovaginal candidiasis among pregnant women in the Ho municipality, Ghana: Species identification and antifungal susceptibility of Candida isolates. BMC Pregnancy Childbirth 2020, 20, 266. [Google Scholar] [CrossRef] [PubMed]
- Cheesbrough, M. District Laboratory Practice in Tropical Countries. Part 2, 2nd ed.; Cambridge University Press Publication: Cape Town, South Africa, 2006; pp. 1–434. [Google Scholar]
- Katibi, O.S.; Aboh, M.I.; Salawu, A.O.; Kola-Mustapha, A.; Olatunji, L.A. Anti-fungal activity of Acalypha wilkesiana: A preliminary study of fungal isolates of clinical significance. Afr. J. Infect. Dis. 2022, 16, 21–30. [Google Scholar] [CrossRef] [PubMed]
- Satyajit, D.; Sarker, A.; Nahar, L.; Kumarasamy, Y. Microtitre plate-based antibacterial assay incorporating resazurin as an indicator of cell growth, and its application in the in vitro antibacterial screening of phytochemicals. Methods 2007, 42, 321–324. [Google Scholar]
- Gandhi, J.V.; Suthar, D.J.; Patel, H.K.; Shelat, P.K.; Parejiya, P.J. Design, fabrication, and evaluation of microemulsion based gel of essential oil of thymus vulgaris for superficial fungal infections. Int. J. Pharm. Sci. Drug Res. 2020, 12, 190–200. [Google Scholar] [CrossRef]

| EO | Color | Clarity | Form | Odor | Solubility | Density (g/mL) |
|---|---|---|---|---|---|---|
| M. alternifolia | Colorless | Clear | Flowing Liquid | Fresh Lemony | + | 0.898 |
| C. flexuosus | Pale yellow | Clear | Flowing Liquid | Fresh-mint | + | 0.984 |
| S/No | Identification Criteria | Characteristics |
|---|---|---|
| 1 | Colonial Morphology | White to cream colored, smooth, yeast-like appearance, and pasty concave colonies |
| 2 | Gram Reaction | Gram positive, budded large oval cells |
| Mean Zone of Inhibition (mm) | ||||||
|---|---|---|---|---|---|---|
| Isolate Code | Concentrations of Essential Oils (µL/mL) | |||||
| Melaleuca alternifolia | Cymbopogon flexuosus | |||||
| 100 | 200 | 300 | 100 | 200 | 300 | |
| CA01 | 12.00 ± 0.00 | + | + | 14.76 ± 0.70 | + | + |
| CA02 | 16.83 ± 0.76 | + | + | 17.50 ± 0.35 | + | + |
| CA14 | 14.16 ± 0.00 | + | + | 17.67 ± 0.70 | + | + |
| CA17 | 14.67 ± 0.70 | + | + | 18.00 ± 0.00 | + | + |
| CA23 | 18.17 ± 0.29 | + | + | 20.00 ± 0.00 | + | + |
| CA28 | 21.00 ± 0.00 | + | + | 22.33 ± 0.58 | + | + |
| CA34 | 16.83 ± 0.76 | + | + | 20.17 ± 0.29 | + | + |
| CA39 | 10.00 ± 0.00 | + | + | 12.83 ± 0.76 | + | + |
| CA42 | 8.16 ± 0.35 | + | + | 9.67 ± 0.58 | + | + |
| CA46 | 8.33 ± 0.70 | + | + | 8.00 ± 0.00 | + | + |
| Typed | 20.00 ± 0.00 | + | + | 21.16 ± 0.29 | + | + |
| Code | MIC (µL/mL) | |
|---|---|---|
| M. alternifolia | C. flexuosus | |
| CA01 | 100 | 100 |
| CA02 | 50 | 25 |
| CA14 | 100 | 50 |
| CA17 | 100 | 100 |
| CA23 | 50 | 50 |
| CA28 | 100 | 100 |
| CA34 | 100 | 100 |
| CA39 | No inhibition | 100 |
| CA42 | No inhibition | 100 |
| CA46 | No inhibition | No inhibition |
| Typed | 50 | 25 |
| C. albicans (Typed) = ATCC 10231 | ||
| Concentration (µL) | 1 100 | 2 50 | 3 25 | 4 12.5 | 5 6.25 | 6 Organism Viability | 7 Essential Oil Sterility | 8 Broth Sterility |
|---|---|---|---|---|---|---|---|---|
| A | + | + | + | - | + | + | - | - |
| B | + | + | + | + | + | + | - | - |
| C | + | + | + | + | + | + | - | - |
| D | + | + | + | + | + | + | - | - |
| E | + | + | + | - | - | + | - | - |
| F | + | + | + | + | + | + | - | - |
| G | + | + | + | - | + | + | - | - |
| H Typed | + | + | + | + | + | + | - | - |
| Concentration (µL/mL) | 1 100 | 2 50 | 3 25 | 4 12.5 | 5 6.25 | 6 Organism Viability | 7 Essential Oil Sterility | 8 Broth Sterility |
|---|---|---|---|---|---|---|---|---|
| A | - | + | + | + | + | + | - | - |
| B | - | + | + | + | - | + | - | - |
| C | - | + | + | + | + | + | - | - |
| D | - | - | + | + | + | + | - | - |
| E | - | - | + | + | + | + | - | - |
| F | - | + | + | + | - | + | - | - |
| G | - | + | + | + | - | + | - | - |
| H Typed | - | - | + | + | - | + | - | - |
| Zones of Inhibition (mm) | |||
|---|---|---|---|
| Essential Oils | 600 µL/mL | 900 µL/mL | 1200 µL/mL |
| Melaleuca alternifolia | 35 | 33.75 | 28.75 |
| Cymbopogon flexuosus | 38 | 14.75 | 60 |
| Combination of the two essential oils | 6.5 | 22.50 | 50 |
| Emulgel only in DMSO | 0.0 | 0.0 | 0.0 |
| Formulations | F1 | F2 | F3 | F4 | F5 |
|---|---|---|---|---|---|
| Color | White | White | White | Faintly yellow | Faintly yellow |
| Texture | Smooth | Smooth | Smooth | Smooth | Smooth |
| Odor | Coconut smell | Coconut smell | Tea tree smell | Lemon grass smell | Lemon grass smell |
| pH | 3.16 | 6.18–6.21 | 3.70–3.74 | 3.81–3.83 | 3.76–3.78 |
| Homogeneity | Good | Good | Good | Good | Very Good |
| Formulation | F1 | F2 | F3 | F4 | F5 |
|---|---|---|---|---|---|
| Appearance | Smooth | Smooth | Smooth | Smooth | Smooth |
| Color | White | White | White | Faintly yellow | Faintly yellow |
| Odor | Coconut smell | Coconut smell | Tea tree smell | Lemon grass smell | Lemon grass smell |
| Homogeneity | Good | Good | Good | Good | Good |
| Texture | Smooth | Smooth | Smooth | Smooth | Smooth |
| Formulation | F1 | F2 | F3 | F4 | F5 |
|---|---|---|---|---|---|
| Appearance | Smooth | Smooth | Smooth | Smooth | Smooth |
| Color | White | White | White | Faintly yellow | Faintly yellow |
| Odor | Coconut smell | Coconut smell | Tea tree smell | Lemon grass smell | Lemon grass smell |
| Homogeneity | Good | Good | Good | Good | Good |
| Texture | Smooth | Smooth | Smooth | Smooth | Smooth |
| Formulation | F1 | F2 | F3 | F4 | F5 |
|---|---|---|---|---|---|
| Appearance | Smooth | Smooth | Smooth | Smooth | Smooth |
| Color | White | White | White | Faintly yellow | Faintly yellow |
| Odor | Coconut smell | Coconut smell | Tea tree smell | Lemon grass smell | Lemon grass smell |
| Homogeneity | Good | Good | Good | Good | Good |
| Texture | Smooth | Smooth | Smooth | Smooth | Smooth |
| Formulation | Torque | Temperature (°C) | RPM | Spindle No | Reading mPas |
|---|---|---|---|---|---|
| F1 | 44.2 | 30.4 | 60 | 4 | 4417.6 ± 8.2 |
| F2 | 86.9 | 30.4 | 60 | 4 | 8694.1 ± 10.3 |
| F3 | 89.9 | 30.6 | 60 | 4 | 8968.7 ± 7.8 |
| F4 | 87.3 | 30.6 | 60 | 4 | 8734.9 ± 9.7 |
| F5 | 89.4 | 30.7 | 60 | 4 | 8946.3 ± 8.8 |
| Ingredients | A | B | C | D | F | G |
|---|---|---|---|---|---|---|
| Tween 80 (g) | 2.56 | 1.60 | 0.64 | 2.88 | 2.24 | 1.92 |
| Span 60 (g) | 5.44 | 3.40 | 1.36 | 6.12 | 4.76 | 4.08 |
| Coconut Oil (g) | 2.00 | 5.00 | 8.00 | 1.00 | 3.00 | 4.00 |
| Water (g) | 4.78 | 1.90 | 2.37 | 13.09 | 12.17 | 8.18 |
| Ingredients | A | B | C | D |
|---|---|---|---|---|
| Xanthan gum (g) | 2.00 | 3.00 | 4.00 | 1.00 |
| Guar gum (g) | 3.00 | 2.00 | 1.00 | 4.00 |
| Water (g) | 45.00 | 45.00 | 45.00 | 45.00 |
| Ingredients | F1 | F2 | F3 | F4 | F5 |
|---|---|---|---|---|---|
| Emulsion (g) | 3.00 | 1.50 | 1.50 | 1.50 | 1.50 |
| Gel (g) | 0.00 | 1.50 | 1.50 | 1.50 | 1.50 |
| Melaleuca alternifolia essential oil (µL) | 0.00 | 0.00 | 1500 | 0.00 | 300 |
| Cymbopogon flexuosus essential oil (µL) | 0.00 | 0.00 | 0.00 | 1500 | 1200 |
Disclaimer/Publisher’s Note: The statements, opinions and data contained in all publications are solely those of the individual author(s) and contributor(s) and not of MDPI and/or the editor(s). MDPI and/or the editor(s) disclaim responsibility for any injury to people or property resulting from any ideas, methods, instructions or products referred to in the content. |
© 2023 by the authors. Licensee MDPI, Basel, Switzerland. This article is an open access article distributed under the terms and conditions of the Creative Commons Attribution (CC BY) license (https://creativecommons.org/licenses/by/4.0/).
Share and Cite
Kola-Mustapha, A.T.; Aliu, M.H.; Bello, R.H.; Adedeji, O.J.; Ghazali, Y.O. The Formulation and Evaluation of Melaleuca alternifolia Cheel and Cymbopogon flexuosus Linn Essential Oils Emulgel for the Treatment of Vulvovaginal Candidiasis. Gels 2023, 9, 949. https://doi.org/10.3390/gels9120949
Kola-Mustapha AT, Aliu MH, Bello RH, Adedeji OJ, Ghazali YO. The Formulation and Evaluation of Melaleuca alternifolia Cheel and Cymbopogon flexuosus Linn Essential Oils Emulgel for the Treatment of Vulvovaginal Candidiasis. Gels. 2023; 9(12):949. https://doi.org/10.3390/gels9120949
Chicago/Turabian StyleKola-Mustapha, Adeola Tawakalitu, Miracle Halima Aliu, Ronke Hadiyat Bello, Oluwakorede Joshua Adedeji, and Yusuf Oluwagbenga Ghazali. 2023. "The Formulation and Evaluation of Melaleuca alternifolia Cheel and Cymbopogon flexuosus Linn Essential Oils Emulgel for the Treatment of Vulvovaginal Candidiasis" Gels 9, no. 12: 949. https://doi.org/10.3390/gels9120949
APA StyleKola-Mustapha, A. T., Aliu, M. H., Bello, R. H., Adedeji, O. J., & Ghazali, Y. O. (2023). The Formulation and Evaluation of Melaleuca alternifolia Cheel and Cymbopogon flexuosus Linn Essential Oils Emulgel for the Treatment of Vulvovaginal Candidiasis. Gels, 9(12), 949. https://doi.org/10.3390/gels9120949

